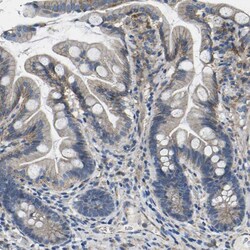
Invitrogen delta Catenin Polyclonal Antibody 100 &mu;L; Unconjugated:Antibodies,

missing translation for 'onlineSavingsMsg'
Learn More
Learn More
Invitrogen™ delta Catenin Polyclonal Antibody
Rabbit Polyclonal Antibody
Brand: Invitrogen™ PA582545
This item is not returnable.
View return policy
Description
Immunogen sequence: SVKEQEAQFE KLTRALEEER RHVSAQLERV RVSPQDANPL MANGTLTRRH QNGRFVGDAD LERQKFSDLK LNGPQDHSHL LYSTIPRMQE PGQIVETYTE EDPEGAMSVV SVETSDDGTT R Highest antigen sequence indentity to the following orthologs: Rat - 98%, Mouse - 98%.
Delta 1 Catenin is an efficient tyrosine kinase substrate implicated both in cell transformation by SRC and in ligand-induced receptor signaling through the EGF, PDGF, CSF-1 and ERBB2 receptors. The association of catenins to cadherins produces a complex which is linked to the actin filament network, and which seems to be of primary importance for cadherins cell-adhesion properties.
Specifications
| delta Catenin | |
| Polyclonal | |
| Unconjugated | |
| CTNND1 | |
| AA409437; AU019353; cadherin-associated Src substrate; Cadherin-associated Src substrate (CAS); CAS; Catenin (cadherin associated protein) delta 1; catenin (cadherin associated protein), delta 1; catenin (cadherin-associated protein), delta 1; catenin delta 1; catenin delta-1; catenin src; catenin, delta 1; Catns; CTNND; Ctnnd1; hypothetical protein; Kiaa0384; mKIAA0384; p120; p120 catenin; P120 CTN; P120 p120; P120 P120CTN; p120(CAS); p120(ctn); P120CAS; p120-catenin; P120CTN | |
| Rabbit | |
| Antigen affinity chromatography | |
| RUO | |
| 12388, 1500, 311163 | |
| Store at 4°C short term. For long term storage, store at -20°C, avoiding freeze/thaw cycles. | |
| Liquid |
| Immunohistochemistry (Paraffin), Western Blot, Immunocytochemistry | |
| 0.4 mg/mL | |
| PBS with 40% glycerol and 0.02% sodium azide; pH 7.2 | |
| O60716, P30999 | |
| CTNND1 | |
| Recombinant protein corresponding to Human CTNND1. Recombinant protein control fragment (Product #RP-90787). | |
| 100 μL | |
| Primary | |
| Human, Mouse, Rat | |
| Antibody | |
| IgG |
Product Content Correction
Your input is important to us. Please complete this form to provide feedback related to the content on this product.
Product Title
Spot an opportunity for improvement?Share a Content Correction